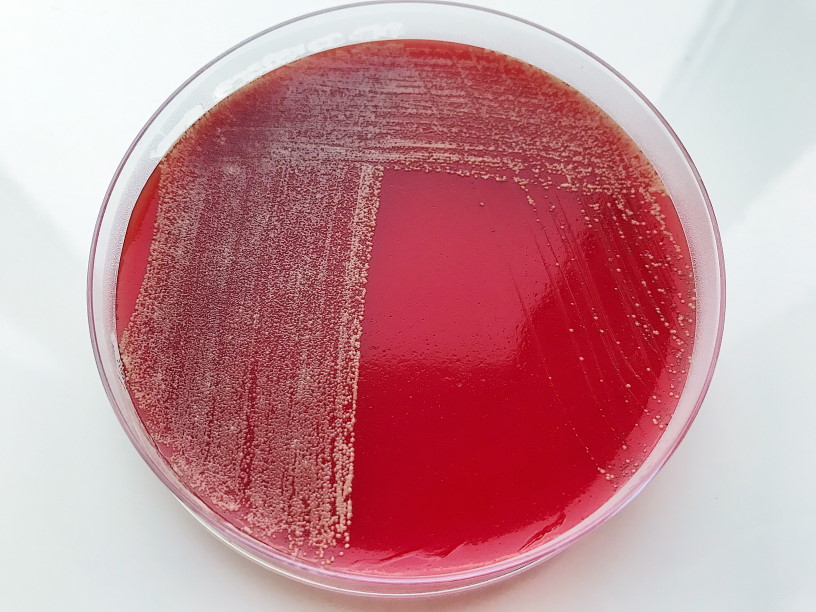

Промикробы: Братство кольца
Думаю, что все или почти все люди знают про чудесную двойную спираль ДНК, которая, как оригами, укладывается в хромосомы, а те, в свою очередь, покоятся в клеточном ядре. Но это верно только для эукариотических клеток, а объекты нашего пристального интереса — бактерии — являются прокариотами. Давайте попытаемся разобраться как у них обстоят дела с ДНК, как и где она упакована.
⠀
В отличие от эукариот, бактерии не имеют ограниченного оболочкой ядра и, в большинстве случаев, каких-либо мембранных органелл, но о них как-нибудь в другой раз. Геномы прокариот включают в себя два типа генетических структур: нуклеоид (аналог хромосомы) и внехромосомные элементы (плазмиды, способные к автономной репликации). Другими словами, есть большая главная часть генома и маленькие, отдельные кусочки.
⠀
Нуклеоид — это неправильной формы зона в цитоплазме прокариотической клетки, в которой находится геномная ДНК и ассоциированные с ней белки. На долю ДНК приходится около 60 % массы нуклеоида; помимо ДНК, нуклеоид содержит РНК и белки. Это аналог клеточного ядра, только без оболочки и формы. В большинстве случаев геном бактерии представлен кольцевой молекулой ДНК, которую также называют хромосомой. Как правило, бактериальная хромосома имеет длину около 1 мм, она занимает до 20 % цитоплазмы. Ряд бактерий имеет и кольцевые, и линейные хромосомы, а некоторые — только линейные. Например, линейная хромосома имеется у возбудителя болезни Лайма.
⠀
Короче, почти как у людей, только хромосома одна, кольцевая и не в ядре. А вот аналога плазмид в эукариотических клетках нет, поэтому про них будет ещё интереснее. Плазмиды — это стабильные элементы внехромосомной ДНК, способные автономно реплицироваться. Как правило, они представляют собой кольцевые молекулы ДНК, но встречаются и линейные плазмиды, по структуре аналогичные линейным хромосомам. В отличие от хромосом, плазмиды являются «необязательным» генетическим материалом, потеря которого не приводит к гибели клетки. Однако многие крупные плазмиды содержат десятки и даже сотни генов, кодирующих важные для клетки функции, которые могут оказаться необходимыми в определенных экологических условиях.
⠀
Некоторые плазмиды могут интегрироваться в хромосому клетки-хозяина и реплицироваться в ее составе. Число копий плазмид в клетке может варьировать в широких пределах, от одной до нескольких сот копий на хромосому, но во всех случаях их количество регулируется, поскольку неограниченная репликация плазмидной ДНК привела бы к гибели клетки. При клеточном делении плазмиды могут распределяться между дочерними клетками случайным образом.
⠀
Гены, содержащиеся на плазмидах, дают своим обладателям полезные свойства, увеличивающие их приспособленность. Например, это могут быть гены, отвечающие за устойчивость к антибиотикам, гены, повышающие устойчивость к тяжёлым металлам и УФ-излучению, гены, кодирующие все компоненты, необходимые для конъюгации. Что такое конъюгация, я расскажу через неделю. А для закрепления темы плазмид я придумала сравнение из мира настольных игр. Плазмиды — это шмот в «Манчкине», который можно заполучить, можно потерять, а пока он у тебя, ты получаешь некое усиление.